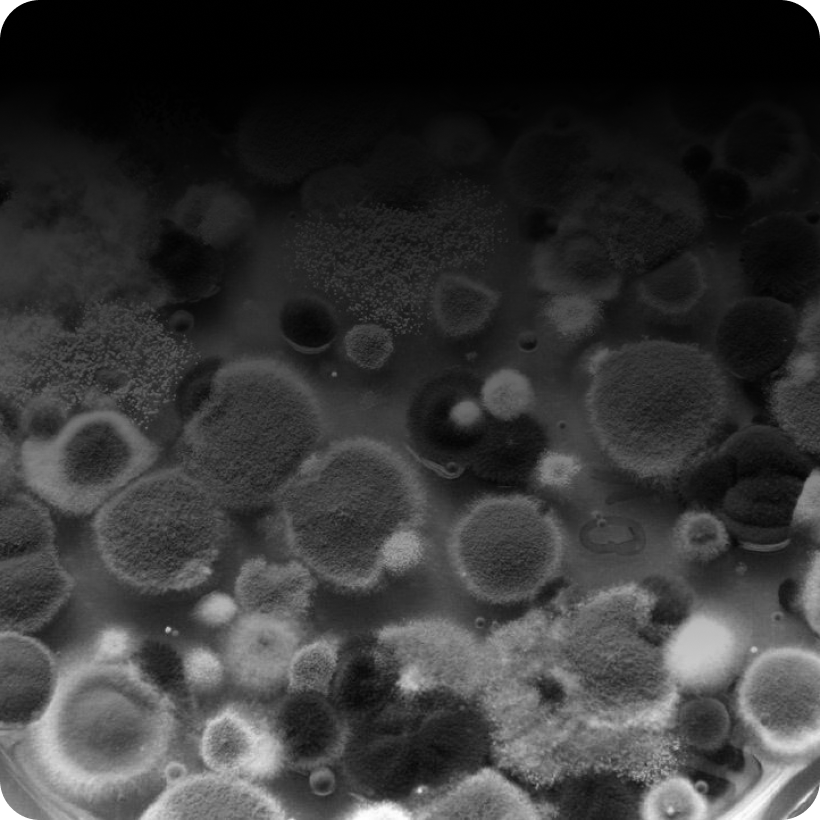

Уничтожение насекомых за 1 час
Бесплатная консультация по телефону
Нажимая на кнопку, вы соглашаетесь с условиями обработки персональных данных
Скачай приложение и используй
300 балов* -Dream Group
300 балов* -Dream Group
*Подробности акции, уточняйте у менеджеров, при заказе услуги по телефону или в мессенджерах.
- Химчистка мебели и ковров после обработки со скидкой 10%
- Бесплатный выезд
- Гарантия до 1 года
От каких проблем можем избавить вас

Дезинфекция
2000 руб.

Обработка от клещей
2000 руб.

Удаление плесени
2000 руб.


Уничтожение клопов
Дезинсекция
2000 руб.
2000 руб.
Уничтожение грызунов

2000 руб.
Уничтожение тараканов
2000 руб.
От каких проблем можем избавить вас

Уничтожение клещей
2000 руб.

Дезинфекция
2000 руб.
Удаление плесени
2000 руб.

Уничтожение грызунов
Дезинсекция
2000 руб.
2000 руб.


Уничтожение тараканов
Уничтожение клопов
2000 руб.
2000 руб.
Бесплатная консультация по телефону
Не стоит откладывать проблему в долгий ящик и и ждать, что все разрешится само собой. Пока насекомые, грызуны, бактерии размножаются, избавиться от них становится все сложнее.
Не откладывайте проблему в долгий ящик - обратитесь к профессионалам!
+ более 50 услуг
Нажимая на кнопку, вы соглашаетесь с условиями обработки персональных данных
Написать нам
Избавим Вас от грызунов в один миг! Дератизация - комплекс мер по уничтожению крыс, мышей и кротов на участке.
К объектам, на которых предписывается обязательное периодическое проведение дератизации, относятся:
К объектам, на которых предписывается обязательное периодическое проведение дератизации, относятся:
- Лечебные учреждения
- Образовательные учреждения
- Заведения общественного питания
- Предприятия пищевой промышленности
- Коммунальные сооружения
Уничтожение грызунов




Не знаете, как бороться с тараканами дома? Мы вам поможем!
Многие пытаются выводить тараканов самостоятельно, однако эффективнее обратиться к профессионалам!
Для уничтожения тараканов специалисты нашей компании используют два метода:
- Уничтожение тараканов генератором горячего тумана
- Выведение тараканов генератором холодного тумана
Используем только эффективные сертифицированные
на территории РФ препараты
Многие пытаются выводить тараканов самостоятельно, однако эффективнее обратиться к профессионалам!
Для уничтожения тараканов специалисты нашей компании используют два метода:
- Уничтожение тараканов генератором горячего тумана
- Выведение тараканов генератором холодного тумана
Используем только эффективные сертифицированные
на территории РФ препараты
Уничтожение тараканов


Обработка квартир от клопов безопасна для детей и животных
и длится не более часа.
Для подготовки квартиры к обработке от клопов необходимо:
Для выведения клопов наша компания использует метод холодного тумана. После дезинсекции против клопов необходимо обязательно проветрить, а также тщательно вымыть все поверхности.
и длится не более часа.
Для подготовки квартиры к обработке от клопов необходимо:
- убрать все продукты питания;
- тщательно упаковать всю бытовую технику, посуду,
- снять со стен картины, ковры, фотографии;
- отодвинуть мебель от стен в центр комнаты.
Для выведения клопов наша компания использует метод холодного тумана. После дезинсекции против клопов необходимо обязательно проветрить, а также тщательно вымыть все поверхности.
Уничтожение клопов с 1-го раза!
Гарантируем качество
своих услуг по договору до 1 года
своих услуг по договору до 1 года
- Мы состоим на учете, как СЭС
- В штате работают более 50 сотрудников
- Все сотрудники проходят постоянную аттестацию в сфере санитарных услуг
- У нас 3 дипломированных врача (санитарный врач, врач-дезинфекционист, врач-эпидемиолог)
- В штате работают более 50 сотрудников
- Все сотрудники проходят постоянную аттестацию в сфере санитарных услуг
- У нас 3 дипломированных врача (санитарный врач, врач-дезинфекционист, врач-эпидемиолог)
Бесплатная консультация по телефону
Нажимая на кнопку, вы соглашаетесь с условиями обработки персональных данных
Написать нам


Безопасное проведение работ по обработке от клещей на участке!
Устраним риск возникновения энцефалита и сыпного тифа благодаря проведению акарицидных работ.
- Применяемые препарты абсолютно безопасны для людей;
- Заключаем договоры на дезинсекцию и с юридическими лицами;
- Работу проводим, учитывая все правила безопасности и предъявляемые требования;
- По необходимости работаем без выходных и в удобное для вас время.
Устраним риск возникновения энцефалита и сыпного тифа благодаря проведению акарицидных работ.
- Применяемые препарты абсолютно безопасны для людей;
- Заключаем договоры на дезинсекцию и с юридическими лицами;
- Работу проводим, учитывая все правила безопасности и предъявляемые требования;
- По необходимости работаем без выходных и в удобное для вас время.
Обработка от клещей
Проводим профессиональные услуги дезинфекции
в жилых квартирах, торговых центрах, промышленных объектах.
Для достижения лучшего эффекта дезинфекции, рекомендуем применение нескольких способов.
Оказываемые услуги по дезинфекции
- дезинфекция детских учреждений;
- дезинфекция автотранспорта;
- дезинфекция точек питания;
- дезинфекция складов;
- дезинфекция офисов.
в жилых квартирах, торговых центрах, промышленных объектах.
Для достижения лучшего эффекта дезинфекции, рекомендуем применение нескольких способов.
Оказываемые услуги по дезинфекции
- дезинфекция детских учреждений;
- дезинфекция автотранспорта;
- дезинфекция точек питания;
- дезинфекция складов;
- дезинфекция офисов.
Дезинфекция




Удаление плесени с гарантией! В своей работе используем только безопасные средства.
Благодаря современному оборудованию можно со сто процентной гарантией выявить места, которые необходимо обработать во избежание появления плесени
Удаление плесени
Избавим Ваше жилище от надоедливых насекомых: клопов, муравьев, тараканов, блох!
Проводим протравливание по специальной эффективной методологии, которая гарантирует полную безопасность и безвредность для человека.
Осуществляем дезинсекцию не только для физических, но и для юридических лиц - проводим обработку на предприятиях.
Проводим протравливание по специальной эффективной методологии, которая гарантирует полную безопасность и безвредность для человека.
Осуществляем дезинсекцию не только для физических, но и для юридических лиц - проводим обработку на предприятиях.
Уничтожение насекомых


Нам доверяют
Отзывы наших клиентов
- Евгений ЛарионовЯ очень доволен услугами этой компании! Они быстро и эффективно провели обработку нашего офиса, что помогло предотвратить распространение вируса среди сотрудников. К тому же, сотрудники компании были профессиональными и дружелюбными, а цены на услуги оказались очень разумными.
- Давид АлирзаевЗаказывал уничтожение тараканов, очень долго мучались с ними самостоятельно, решили наконец обратиться в специализированную службу, и вот уже целый месяц никаких тараканов, мы с женой в восторге!!! Спасибо Вам большое
- Владимир РедьковКаждый сезон обрабатываем участок нашего дома от клещей - хотим обезопасить себя, детей и домашних животных. Благодаря Вам мы можем спокойно разрешать детям играть и бегать по траве, не опасаясь последствий.

Оставьте ваши контакты
Наши специалисты с вами сейчас свяжутся
Нажимая на кнопку, вы соглашаетесь с условиями обработки персональных данных









